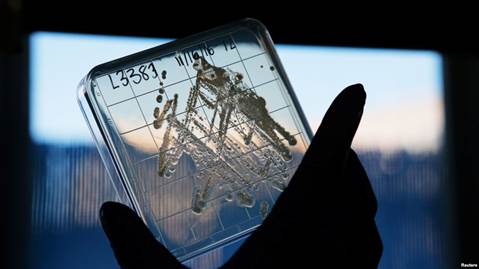

Ngày 4/3/2017. WASHINGTON-Các bác sĩ cảnh báo về một thời kỳ hậu kháng sinh (Doctors Alarmed by Post-antibiotic Future). Trừ khi các thuốc kháng sinh mới được phát triển một cách nhanh chóng nếu không con người sẽ lại chết một lần nữa vì các nhiễm trùng thông thường, Tổ chức Y tế thế giới (WHO) đã ban hành một lời kêu gọi khẩn cấp cho các nhà khoa học phát triển các loại thuốc mới và các chính phủ tài trợ cho việc nghiên cứu.
TS. Trish Perl, giám đốc các bệnh truyền nhiễm tại Trung tâm y tế Tây Nam thuộc Đại học Texas cho biết nếu không có các thuốc kháng sinh hiệu quả thì nó sẽ ảnh hưởng đến toàn bộ thực hành nghề y: "Nếu bạn bất ngờ biết được những gì giống như thực hành y tế có thể 50, 70, 80 năm trước đây thì điều đó là do không có thuốc kháng sinh".Nếu không có kháng sinh phẫu thuật sẽ trở nên nguy hiểm hơn nhiều, các bác sĩ sẽ không thể điều trị các bệnh do E.coli, một loại vi khuẩn gây nhiễm trùng đường tiết niệu và tiêu chảy. Ngay cả một virus như cúm, có thể dẫn đến viêm phổi do vi khuẩn đồng nghĩa cuối cùng những loại virus này sẽ cướp đi mạng sống nhiều hơn.
Các thuốc kháng sinh mới là cần thiết (New antibiotics needed)
Các thuốc kháng sinh mới là thực sự cần thiết nhằm chống lại các vi khuẩn gây ra mối đe dọa lớn nhất đối với sức khỏe con người, những người có nguy cơ cao nhất: cư dân của nhà dưỡng lão, bệnh nhân ở bệnh viện, và trẻ em. Trẻ em có thể có hệ thống miễn dịch yếu hơn so với người lớn, và chúng nhận được các liều thuốc kháng sinh nhở hơn so với người lớn. TS. Michael Bell, một chuyên gia về các mầm bệnh kháng thuốc tại Trung tâm kiểm soát và phòng ngừa dịch bệnh Hoa Kỳ (USCDC) nói với đài VOA: "Trong một thời gian rất dài, chúng ta có một số kháng sinh khác nhau sẵn sàng tại bất kỳ thời điểm nào cần vì vậy bất cứ khi nào chúng ta không còn khả năng sử dụng loại kháng sinh này thì chúng ta sẽ chuyển đến sử dụng loại kháng sinh tiếp theo" nhưng điều đó có thể không còn nữa. Joe Larsen-giám đốc cơ quan ứng phó về sinh học, hóa học và phóng xạ và hạt nhân tại Bộ Y tế và Dịch vụ nhân sinh cho biết cơ quan của ông lập nên một danh sách các tác nhân gây bệnh từ nhiều năm trước đó mà đang đề kháng với các thuốc kháng sinh.
Một nhà nghiên cứu tại công ty dược phẩm NovoBiotic đang giữ một mẫu vi khuẩn Eleftheria Terrae,
cơ sở cho một loại kháng sinh triển vọng Teixobactin, ở Cambridge, Massachusetts, ngày 22/11/2016.
Kinh phí cần phải thay đổi (Funding needs to change)
Joe Larsen nói: "Có nhiều loại thuốc kháng sinh sẵn có nhưng số lượng không đủ ... để đối phó với tỷ lệ ngày càng tăng của vi khuẩn đề kháng với kháng sinh".Cơ quan của Larsen đầu tư vào các công ty dược phẩm và công nghệ sinh học để tạo ra nhiều loại thuốc, vaccine và công cụ chẩn đoán chuẩn bị cho các tình trạng khẩn cấp y tế công cộng. Larsen hy vọng rằng một loại kháng sinh mới sẽ được phê chuẩn bởi Cục Quản lý thực phẩm và dược phẩm (FDA) vào cuối năm nay, ông cũng cho biết 2-3 loại kháng sinh đang được phát triển và sẽ có sẵn trong vòng một hoặc hai năm tới.WHO cho biết quá tốn kém đối với các công ty dược phẩm để phát triển các loại thuốc kháng sinh mới của riêng họ vì họ sẽ không thu lại nguồn đầu tư, Larsen đồng ý rằng cách mà thuốc kháng sinh bị thương mại hóa cần phải thay đổi.

Trụ sở của WHO được chụp tại Geneva, Thụy Sĩ, ngày 22/3/2016
Vi khuẩn đang thay đổi liên tục (Bacteria are constantly changing)
Một lý do là một kháng sinh được sử dụng càng nhiều thì kháng sinh đó ngày càng ít hiệu quảvì vi khuẩn đang thay đổi liên tục và tìm ra những cách thức mới để chống lại các loại thuốc diệt chúng, một khi chúng tìm thấy một cách nào đó, chúng có thể truyền qua trên các gen nên các vi khuẩn khác cũng có thể trở nên đề kháng với thuốc.Để duy trì hiệu quả của một loại thuốc kháng sinh, Larsen cho biết lợi nhuận từ việc bán những loại thuốc này có thể không được liên kết với khối lượng bán hàng cách mà thị trường thường hoạt động, các giải pháp nằm trong quan hệ đối tác công-tư giữa chính phủ và các công ty dược phẩm hoặc các công ty công nghệ sinh học.Trong khi đó, sự đề kháng kháng sinh là rất thực.Lauri Hicks, chủ trì nghiên cứu về sử dụng kháng sinh và các khuynh hướng kháng kháng sinhtại USCDC cho biết: "Chỉ riêng tại Hoa Kỳ,chúng tôi đang thấy trên 2 triệu ca kháng kháng sinh mỗi năm và 23 ngàn ca nhiễm trùng trong số này dẫn đến tử vong".

Trụ sở của USCDCở Atlanta.
Đừng lạm dụng thuốc kháng sinh (Don’t overuse antibiotics)
USCDCđã yêu cầu các bệnh viện và các bác sĩ phải cẩn thận và không lạm dụng thuốc kháng sinh nhưng Bell của CDC cho rằngviệc lạm dụng quá mức do những lý do khác làm cho những loại thuốc này ngày càng trở nên không còn hiệu quả. Ông nói: "Kháng kháng sinh đang được tạo ra không chỉ vì sử dụng quá nhiều loại thuốc kháng sinh mà còn bởi sự lây lan của nhiễm trùng do thiếu vệ sinh, tiếp xúc ngoài ý muốn với các bề mặt bẩn vì vậy việc kiểm soát lây nhiễm cũng không kém phần quan trọng".Bệnh nhân cũng có thể giúp giải quyết vấn đề nay, USCDC cho biết trên website của mìnhdùng các thuốc kháng sinh theo đơn và hoàn thành liệu trình theo đơn ngay cả khi bạn cảm thấy tốt hơn nhưng hành động khẩn cấp trên một cấp độ toàn cầu là cần thiết để ngăn chặn thảm họa mà một kỷ nguyên hậu kháng sinh sẽ gây ra.